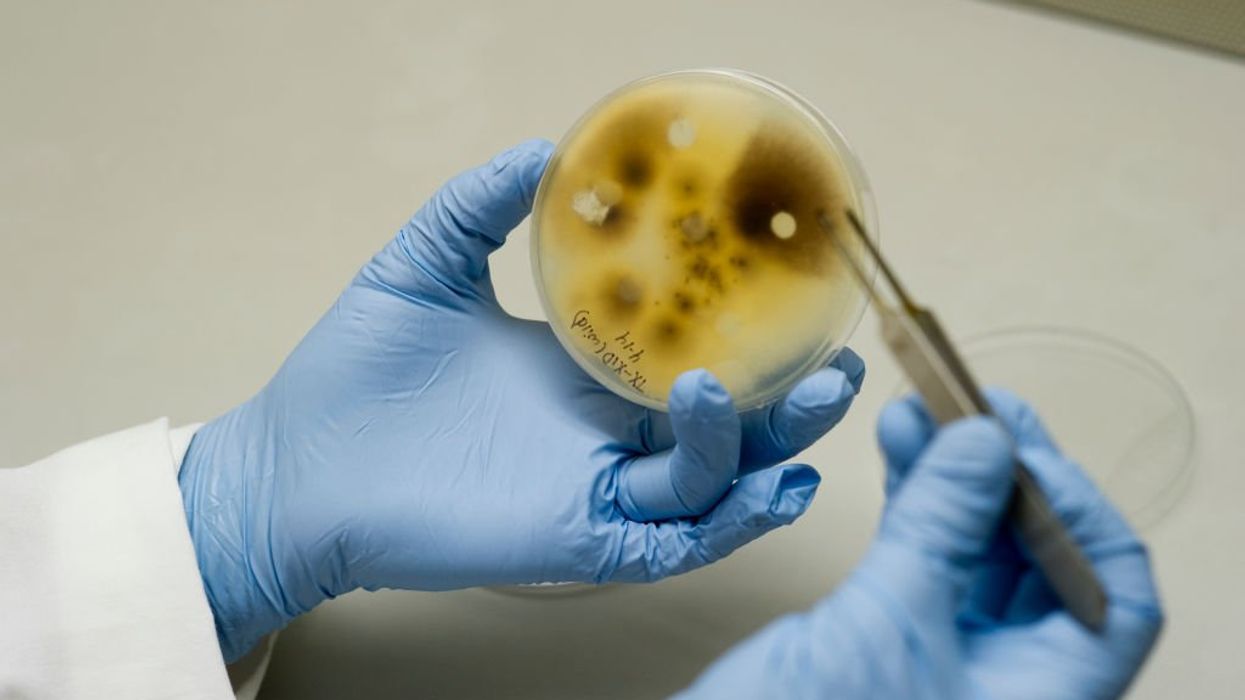

Photo by: Edwin Remsburg/VW Pics via Getty Images
Education Department targets the University of Michigan over alleged issues with foreign gifts tied to China.
A university has become the target of a federal investigation following an alarming pattern of potential national security threats.
In June, two Chinese scholars with ties to the University of Michigan were charged with attempting to smuggle a biological pathogen that could devastate crops into the United States. The suspects claimed they wanted to use the fungus, Fusarium graminearum, to conduct research at the university's laboratory.
'As the recipient of federal research funding, UM has both a moral and legal obligation to be completely transparent about its foreign partnerships.'
Interim U.S. Attorney Jerome Gorgon described the pathogens as a "potential agroterrorism weapon."
One week later, federal authorities arrested another Chinese scholar with ties to the university on similar charges. The suspect was accused of mailing packages containing "biological material related to round worms" from Wuhan to the Michigan university.
The recent arrests appear to have prompted the Trump administration's Department of Education to open an investigation into the University of Michigan for allegedly violating federal disclosure laws.
A Tuesday letter from Education Department officials to UM interim President Domenico Grasso claimed that the university provided "incomplete, inaccurate, and untimely" disclosures of foreign gifts and contracts related to Chinese research. The university disclosed $375 million since January 2021, and roughly $86 million, or over 20%, was allegedly provided in an untimely manner.
The letter further stated that the university "erroneously identified" the counterparty as "nongovernmental" in "many" of its disclosure reports.
RELATED: From Wuhan to Michigan: Feds nab ANOTHER Chinese scholar in alleged bio-material smuggling plot

The Education Department Chief Investigative Counsel Paul Moore stated, "Despite the University of Michigan's history of downplaying its vulnerabilities to malign foreign influence, recent reports reveal that UM's research laboratories remain vulnerable to sabotage, including what the U.S. Department of Justice recently described in criminal charges as 'potential agroterrorism' by Chinese nationals affiliated with UM. As the recipient of federal research funding, UM has both a moral and legal obligation to be completely transparent about its foreign partnerships."
"Unfortunately, tens of millions of dollars in foreign funding in UM's disclosure reports have been reported in an untimely manner and appear to erroneously identify some of UM's foreign funders as 'nongovernmental entities,' even though the foreign funders seem to be directly affiliated with foreign governments. [The Education Department's Office of General Counsel] will vigorously investigate this matter to ensure that the American people know the true scope of foreign funding and influence on our campuses."
RELATED: Agroterrorism plot? Chinese nationals arrested for smuggling potential bioweapon into US: FBI

Colleen Mastony, UM's assistant vice president for public affairs, told the Detroit News that it "is dedicated to advancing knowledge, solving challenging problems, and improving nearly every facet of the human experience. Our research enterprise is united in this commitment to serving the people of Michigan and the world."
"The University of Michigan takes its responsibility to comply with the law extremely seriously, and we will cooperate fully with federal investigators. We strongly condemn any actions that seek to cause harm, threaten national security, or undermine the university's critical public mission," Mastony added.
Like Blaze News? Bypass the censors, sign up for our newsletters, and get stories like this direct to your inbox. Sign up here!